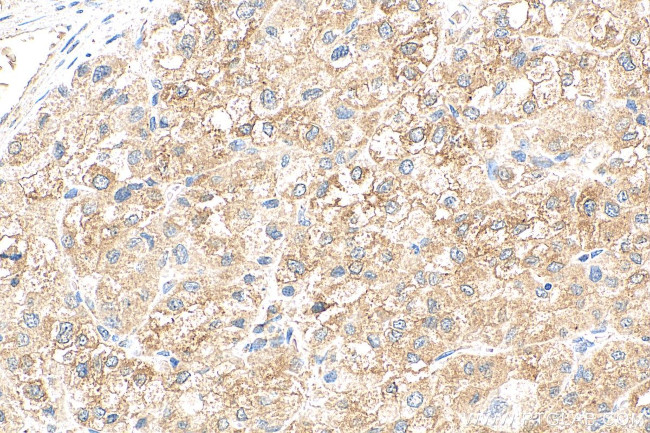
MYDGF/C19orf10 Antibody in Immunohistochemistry (Paraffin) (IHC (P))

Search
Proteintech
MYDGF/C19orf10 Monoclonal Antibody (1H8F4)
{{$productOrderCtrl.translations['antibody.pdp.commerceCard.promotion.promotions']}}
{{$productOrderCtrl.translations['antibody.pdp.commerceCard.promotion.viewpromo']}}
{{$productOrderCtrl.translations['antibody.pdp.commerceCard.promotion.promocode']}}: {{promo.promoCode}} {{promo.promoTitle}} {{promo.promoDescription}}. {{$productOrderCtrl.translations['antibody.pdp.commerceCard.promotion.learnmore']}}
图: 1 / 3
MYDGF/C19orf10 Antibody (68131-1-IG150UL) in IHC (P)



产品信息
68131-1-IG150UL
种属反应
宿主/亚型
分类
类型
克隆号
偶联物
形式
浓度
规格
纯化类型
保存液
内含物
保存条件
运输条件
靶标信息
The interleukins are a broad family of well characterized cytokines, primarily of hematopoietic cell origin. Cytokines are small, soluble proteins with pleiotropic effects on a variety of cell types. Cytokines have a regulatory function over the immune system and mediate aspects of inflammatory response. IL-25 (also called SF20/IL-25) is a secreted bone marrow stroma-derived growth factor cytokine that is derived from Th2 T-cells. IL-25 belongs to the IL-17 cytokine family and is capable of amplifying allergic type inflammatory responses by its actions on other cell types. IL-25 binds to mouse thymic shared antigen-1 and supports lymphoid cell proliferation. Infusion of mice with IL-25 induces IL-4, IL-5, and IL-13 gene expression. IL-25 induced mice also develop epithelial cell hyperplasia, increased mucus secretion, and airway hyperreactivity, suggesting that IL-25 may be an important mediator of allergic disease via production of IL-4, IL-5, IL-13 and eotaxin.
仅用于科研。不用于诊断过程。未经明确授权不得转售。
篇参考文献 (0)
生物信息学
蛋白别名: CS010; IL 25; IL 27; interleukin 27 working designation; interleukin-25; Interleukin25; MYDGF; Myeloid-derived growth factor; R33729 1; R337291; similar to lymphocyte antigen 6 complex, locus E ligand; stromal cell-derived growth factor SF20; UPF0556 protein C19orf10; UPF0556 protein C19orf10 homolog
基因别名: C19orf10; D17Wsu104e; EUROIMAGE1875335; IL25; IL27; IL27w; Ly6elg; MYDGF; R33729_1; SF20
UniProt ID: (Human) Q969H8, (Mouse) Q9CPT4
Entrez Gene ID: (Rat) 501282, (Human) 56005, (Mouse) 28106